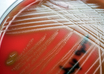

Streptococcus suis, a species of bacterium found in many parts of world
UNI | Jul 06, 2018
Sleep disorder linked with brain changes found in dementia
IANS | Jul 06, 2018
Scientists develop potential approach to treat dementia, stroke
IANS | Jul 06, 2018
Mother's lifestyle choices linked to obesity risk in adolescents
IANS | Jul 06, 2018
Feeling young could slow down brain ageing: Study
IANS | Jul 06, 2018
Innovative synthesis strategy opens door to new medicinal compounds
ANI | Jul 05, 2018
How ‘skinny fat’ can predict Alzheimer's disease
ANI | Jul 05, 2018
New clues to sepsis may speed diagnosis
ANI | Jul 05, 2018
Men at more risk for neurodevelopment disorder than women
ANI | Jul 05, 2018
Hypertensive patients need not worry about treatment anymore
ANI | Jul 05, 2018
Most read this week